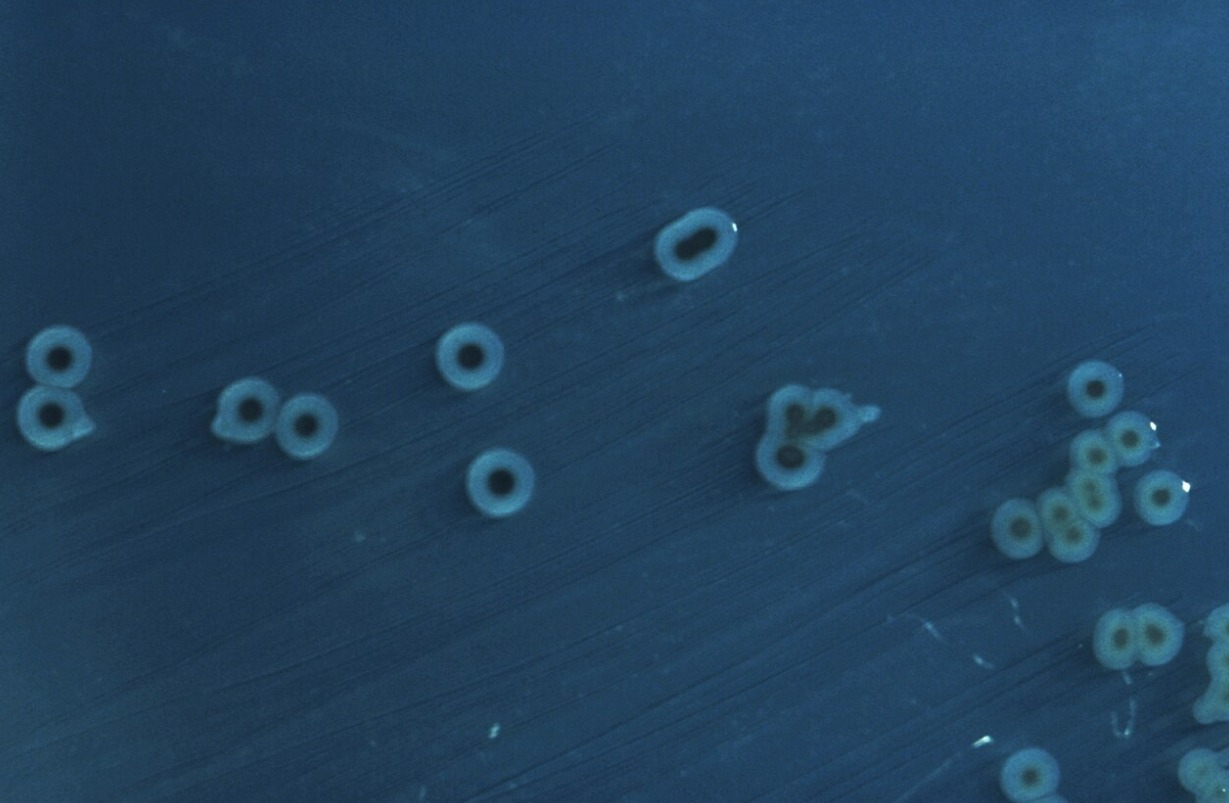
Что такое брюшной тиф. Колония возбудителей брюшного тифа, Источник изображения: wikipedia.org. Фото.

Typhoid vaccination at a rural school. Image source: wikimedia.org
It might seem like typhoid fever is a disease from history textbooks — something from the era of poor sanitation and world wars. In developed countries, it’s almost forgotten. But this ancient killer hasn’t gone anywhere, and it is now rapidly learning to resist all known antibiotics. The results of a large-scale genetic study have shown that typhoid superbugs are already spreading across the globe, and medicine is left with literally one last drug.
What Is Typhoid Fever
Typhoid fever is caused by the bacterium Salmonella enterica subsp. enterica. It attacks the intestines, enters the bloodstream, and without treatment kills one in five infected people. The disease is accompanied by high fever, severe headache, diarrhea, and general exhaustion of the body. Every year, according to WHO data, approximately 9 million people contract typhoid fever, and up to 110,000 of them die.
In countries with clean water and developed sewage systems, typhoid is rare. But in South Asia, especially in India, Pakistan, Bangladesh, and Nepal, it remains an everyday threat. The bacterium is transmitted through contaminated water and food, and in overcrowded cities lacking sanitary infrastructure, this means a constant cycle of infection. For decades, antibiotics remained the only reliable weapon against typhoid. And it is precisely this weapon that is rapidly losing its effectiveness.
Colony of typhoid fever pathogens. Image source: wikipedia.org
How the Typhoid Bacterium Became Antibiotic-Resistant
In 2022, an international team of scientists published a large-scale study in the journal The Lancet Microbe. They sequenced the genomes of 3,489 strains of typhoid bacteria collected between 2014 and 2019 in four South Asian countries. The results were alarming.
It turned out that so-called XDR strains (those with resistance to a broad spectrum of antibiotics) are rapidly displacing ordinary ones. These superbugs do not respond to treatment with an entire arsenal of drugs: ampicillin, chloramphenicol, trimethoprim, fluoroquinolones, and even third-generation cephalosporins. Simply put, almost everything doctors have been accustomed to using to treat typhoid fever has stopped working.
The first XDR strain was discovered in Pakistan in 2016. By 2019, it had already become the dominant genotype in the country. For comparison: it takes ordinary influenza decades to significantly change its genetic profile. But here — three years, and the bacterium completely restructured itself.
Why Typhoid Fever Is Spreading Across the World
The most frightening aspect of this study is not just the speed of mutations, but the geography. Although most XDR cases have been recorded in South Asia, scientists identified nearly 200 episodes of international spread of resistant strains since 1990. The superbugs have already reached Southeast Asia, East and Southern Africa, and have also been detected in the United Kingdom, the United States, and Canada.
How does this happen? It’s quite simple: international flights, migration, tourism. A person gets infected in Karachi (Pakistan), boards a plane, and 10 hours later arrives in London. The bacterium flies business class and doesn’t care what passport the carrier holds.
The speed at which highly resistant strains of typhoid have emerged and spread in recent years is a serious concern, — noted Jason Andrews, an infectious disease specialist at Stanford University.
But there is a nuance that makes the situation even more dangerous. By the early 2000s, mutations conferring resistance to antibacterial drugs were already found in more than 85% of all typhoid cases in Bangladesh, India, Pakistan, Nepal, and Singapore.

Symptoms of typhoid fever. Image source: bigenc.ru
What Is the Last Remaining Drug Against Typhoid
As of today, only one oral antibiotic is effective against XDR typhoid — azithromycin, belonging to the macrolide class. This is literally the last line of defense. And it’s already cracking.
The 2022 study showed that mutations conferring resistance to azithromycin have also begun to spread. Their share is still small for now, but the trend is clear: the bacterium is moving toward becoming completely invulnerable to all available oral antibiotics. If this happens, typhoid can only be treated with intravenous drugs in hospital settings — something impossible to provide at scale in impoverished regions with millions of patients.
Scientists are urging the urgent expansion of vaccination programs. Effective typhoid vaccines exist, including the Typhoid Conjugate Vaccine (TCV), recommended by the WHO since 2018. But the problem is that vaccination covers only a small portion of the population in at-risk zones. Investments in water supply, sanitation, and epidemiological surveillance systems are also needed.
What the Threat of Antibiotic-Resistant Bacteria Means
Antibiotic resistance is not an abstract problem from scientific journals. According to estimates by The Lancet, in 2019, antibiotic-resistant bacterial infections caused approximately 1.27 million deaths worldwide. That’s more than malaria and HIV combined. And typhoid is just one piece of this puzzle.
For residents of developed countries, the immediate threat is still relatively low: quality water and sanitation protect against infection. But the world is more connected than ever. A single trip to an endemic region is enough to bring home a strain that cannot be treated with anything from the pharmacy shelf.
The main thing to understand: this is not a reason to panic, but a serious warning. Bacterial evolution will not stop on its own, and viruses and bacteria need to be monitored proactively — not when the last drug stops working. The case of typhoid is a vivid reminder: infections we considered defeated know how to come back. And they come back stronger.